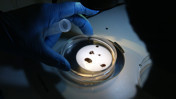
Yeni bir kene türü keşfedildi! Sağlık Bakanlığı'ndan Aydınlık'a özel açıklamalar...

TURKOVAC'ı geliştiren üniversite KKKA aşısı üretecek!
TURKOVAC aşısını geliştiren Erciyes Üniversitesi Aşı Araştırma ve Geliştirme Uygulama ve Araştırma Merkezi (ERAGEM), şimdi de Kırım Kongo Kanamalı Ateşi (KKKA) hastalığına karşı aşı geliştiriyor. ERAGEM Müdürü Prof. Dr. Aykut Özdarendeli, aşı hakkında ayrıntıları anlattı.

TURKOVAC aşısını geliştiren Erciyes Üniversitesi Aşı Araştırma ve Geliştirme Uygulama ve Araştırma Merkezi (ERAGEM) Müdürü Prof. Dr. Aykut Özdarendeli, Kırım Kongo Kanamalı Ateşi (KKKA) hastalığına karşı geliştirilen aşının klinik öncesi çalışmalarını eylüle kadar bitirmeyi planladıklarını bildirdi. Özdarendeli, bir halk sağlığı problemi olan KKKA'nın 2002'den itibaren Türkiye'de görüldüğünü söyledi.
Özdarendeli, kene vakalarında çok fazla artış söz konusu olmadığını, insanların spekülasyonlara dikkat etmesi gerektiğini ve bu hastalığa karşı artık tam ve net bir çözüm bulmak istediklerini sözlerine ekledi.
'AŞI ÇALIŞMALARINA YENİDEN BAŞLADIK'
AA'ya konuşan Özdarendeli, KKKA ile ilgili aşı çalışmalarına uzun süre önce başladıklarını hatırlatarak Kovid-19 aşısı geliştirmek için 2020-2023 yılları arasında ara verdikleri çalışmalara geçen yıl yeniden başladıklarını dile getirdi.
Özdarendeli, şunları kaydetti:
"Hem Erciyes Üniversitesinin hem de Sağlık Bakanlığı TÜSEB'in desteklediği proje var. Bu proje eylül ayında bitiyor. Eylüle kadar klinik öncesi çalışmaları bitirmeyi planlıyoruz. Zaten çok az kaldı. Aynı Kovid-19 sürecinde olduğu gibi projenin hizmet alımı kapsamında TURKOVAC aşısını endüstriyel boyutta üreten firmaların şartlarında çalışmalara devam ediyoruz. Tabii her şey yolunda gittiği ve Sağlık Bakanlığı da faz çalışmalarına geçmeyi uygun bulduğu zaman bu senenin sonuna doğru faz çalışmalarına başlayacağız diye düşünüyorum."

'TURKOVAC'DA DENEYİM ELDE ETTİK'
Aşı çalışmalarında tecrübenin önemine dikkati çeken Özdarendeli, "Şimdi TURKOVAC aşısından elde ettiğimiz deneyimler, KKKA aşısıyla ilgili önemli olacak. Zaten klinik öncesi çalışmalardan faz çalışmalarına kadar her aşamanın Türkiye'de yapıldığı bir deneyim geçirdik. Bu konuda sadece biz değil, birçok paydaş var. Sağlık Bakanlığı, Erciyes Üniversitesi ve özel sektör var. Bu anlamda çok daha tecrübeliyiz ve ülke olarak neler yapılabileceğimizi gösterdik." dedi.
Özdarendeli, birkaç kişilik takviyenin yapıldığı TURKOVAC'ı başarıyla geliştiren ekibin şimdi KKKA hastalığına karşı aşının geliştirilmesi için çalışma yaptığını ifade etti.
'4-5 YIL GİBİ BİR SÜREDE PİYASAYA ÇIKABİLİR'
Faz çalışmalarının önemli olduğunu vurgulayan Özdarendeli, "Bu denemelerin yapılmasının sebebi, aşının etkin ve güvenli olduğunu göstermesi. Faz çalışmaları için çok tarih vermek istemiyorum ama her şey yolunda giderse en geç 4-5 yıl gibi bir sürede önemli bir noktaya geleceğimizi ve aşının piyasaya çıkabileceğini düşünüyorum." diye konuştu.
Aşı çalışmalarında iş birliği yaptıkları kurumlar olduğunu aktaran Özdarendeli, şöyle devam etti:
"Erciyes Üniversitesi zaten belirli şekilde destekliyor bizi. YÖK, ADEP projeleriyle destekliyor, burada belirli bir noktaya geldik. Asıl bu konudaki destek Sağlık Bakanlığı ve TÜSEB tarafından veriliyor. Aynı zamanda bu noktaya gelmemizde de yine TÜBİTAK 1003 projesini bitirdik. İşin altyapısı ve ilk çalışmalar bu projeyle yapıldı. Yani söylediğim gibi TÜSEB, TÜBİTAK ve Erciyes Üniversitesi neticede bu projeleri destekledi ve bu noktaya kadar geldik. Farklı alanlarda farklı üniversitelerle, gruplarla özellikle araştırma noktalarında işbirliklerimiz devam ediyor."
 Vücutta en çok o bölgeye yapışıyor: Kene ısırıklarına sakın bu hatayı yapmayın!Yerel Haberler
Vücutta en çok o bölgeye yapışıyor: Kene ısırıklarına sakın bu hatayı yapmayın!Yerel Haberler Yeni bir kene türü keşfedildi! Sağlık Bakanlığı'ndan Aydınlık'a özel açıklamalar...Sağlık
Yeni bir kene türü keşfedildi! Sağlık Bakanlığı'ndan Aydınlık'a özel açıklamalar...Sağlık



